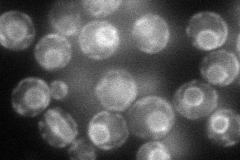
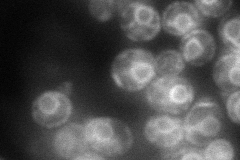
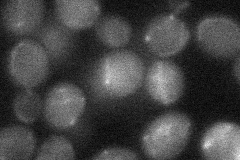
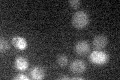

View description
Golgi membrane protein involved in manganese homeostasis; overproduction suppresses the sod1 (copper, zinc superoxide dismutase) null mutation
Localization:
Intensity:
Fold change:
Significance:
-
C’ GFP library in SD

below threshold15.11 -
N' NOP1pr-GFP in SD
ER72.5797 -
N' TEF2pr-mCherry in SD
ER71.7763 -
N' NATIVEpr-GFP in SD

ER25.0398 -
N' TEF2pr-VC and Cyto-VN in SD
below threshold21.8322 -
C’ GFP library in SD+DTT

cytosol16.211.07No -
C’ GFP library in SD+H2O2

cytosol15.671.03No -
C’ GFP library in Starvation Media
cytosol17.31.14No -
C’ GFP library on the background of Pup2-DaMP

below threshold -
C’ GFP library on the background of CCT mutant

below threshold14.76160.976289No
